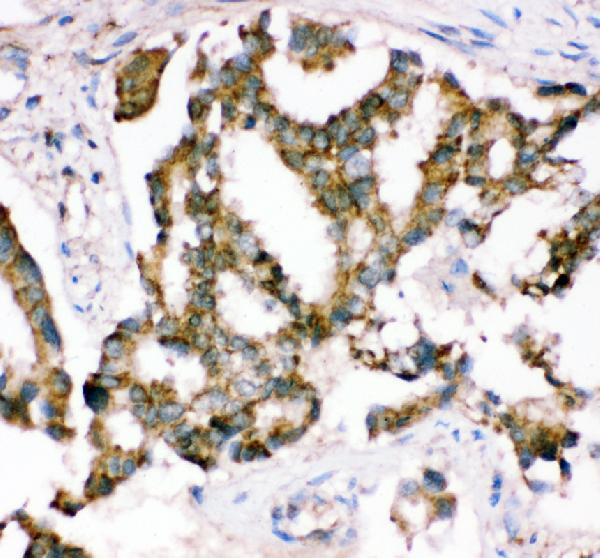
CRK Antibody in Immunohistochemistry (Paraffin) (IHC (P))

Search
Invitrogen
CRK Polyclonal Antibody
{{$productOrderCtrl.translations['antibody.pdp.commerceCard.promotion.promotions']}}
{{$productOrderCtrl.translations['antibody.pdp.commerceCard.promotion.viewpromo']}}
{{$productOrderCtrl.translations['antibody.pdp.commerceCard.promotion.promocode']}}: {{promo.promoCode}} {{promo.promoTitle}} {{promo.promoDescription}}. {{$productOrderCtrl.translations['antibody.pdp.commerceCard.promotion.learnmore']}}
图: 1 / 5
CRK Antibody (PA5-79067) in IHC (P)





Please note: We are reviewing Western blot images included in the antibody testing data in our catalog, including those provided by third parties. Unless expressly labeled or annotated as “raw-unedited”, Western blot images included in the antibody testing data in our catalog may have been edited, optimized or otherwise adjusted for presentation.
产品信息
PA5-79067
种属反应
宿主/亚型
分类
类型
抗原
偶联物
形式
浓度
规格
纯化类型
保存液
内含物
保存条件
运输条件
RRID
产品详细信息
Reconstitute with 0.2 mL of distilled water to yield a concentration of 500 µg/mL.
Positive Control - WB: human 293T whole cell, human A549 whole cell, rat liver tissue, mouse liver tissue. IHC: human lung cancer tissue, mouse brain tissue, rat brain tissue.
靶标信息
The Crk-I and Crk-II forms differ in their biological activities. Crk-II has less transforming activity than Crk-I. Crk- II mediates attachment-induced MAPK8 activation, membrane ruffling and cell motility in a Rac-dependent manner. Involved in phagocytosis of apoptotic cells and cell motility via its interaction with DOCK1 and DOCK4. May regulate the EFNA5-EPHA3 signaling.
仅用于科研。不用于诊断过程。未经明确授权不得转售。
篇参考文献 (0)
生物信息学
蛋白别名: Adapter molecule crk; avian sarcoma virus CT10 (v-crk) oncogene homolog; CRK1; CSAID-binding protein; Csaids binding protein; CT-10 related kinase 3; cytokine suppressive anti-inflammatory drug binding protein; cytokine suppressive anti-inflammatory drug binding protein 1; Cytokine suppressive anti-inflammatory drug-binding protein; cytokine-supressive anti-inflammatory drug binding protein; MAP kinase 14; MAP kinase 2; MAP kinase MXI2; MAP kinase p38 alpha; MAPK 14; MAX-interacting protein 2; mitogen activated protein kinase 14; Mitogen-activated protein kinase 14; mitogen-activated protein kinase 14A; Mitogen-activated protein kinase p38 alpha; p38; p38 alpha; p38 MAP kinase; p38 MAP kinase alpha; p38 MAPK; p38 mitogen activated protein kinase; p38alpha Exip; Proto-oncogene c-Crk; reactive kinase; SAPK2a; Stress-activated protein kinase 2a; tRNA synthetase cofactor p38; v-crk sarcoma virus CT10 oncogene homolog; v-crk sarcoma virus CT10 oncogene-like protein
基因别名: c-Crk; CRK; Crk-I; Crk-II; Crk-III; CRK1; Crk3; CrkIII; Crko; CSBP; CSBP1; CSBP2; CSPB1; Exip; Hog; MAPK14; MXI2; p38; p38-alpha; p38a; p38alpha; p38Hog; p38MAPK; PRKM14; PRKM15; RK; SAPK2A
UniProt ID: (Mouse) Q64010, (Rat) Q63768, (Mouse) P47811
Entrez Gene ID: (Mouse) 12928, (Rat) 54245, (Rat) 81649, (Mouse) 26416